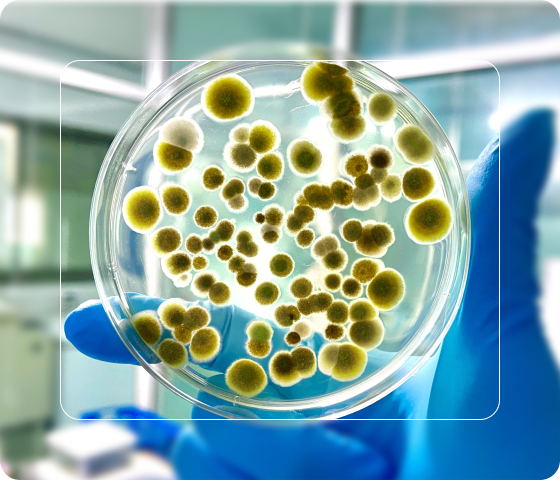
functional health

A Clear, Science-Based Approach to Mental Health
Instead of trial and error, we begin with labs. Your results give us a clear picture of what your body needs so we can design a targeted treatment plan grounded in real data—not guesses.

Uncovering the Root Causes of Mental Health Symptoms
Many people are told their labs are “normal,” yet they still don’t feel well. Instead of stopping there, we look deeper. Advanced functional and genetic testing helps identify the hidden factors that influence mood, energy, focus, and overall well-being.
These results are a key part of The BLISS Protocol, allowing us to design a treatment plan that reflects your unique biology—not generic symptom patterns.
Traditional lab work often catches only major abnormalities. Functional testing reveals subtler imbalances that still have a meaningful impact on how you feel.
We evaluate markers connected to:
- Nutrient deficiencies linked to mood and cognition
- Hormone imbalances that influence stress, sleep, and emotional health
- Inflammation associated with depression, fatigue, and brain fog
- Genetic factors that affect your response to medications and supplements
- Gut health issues that disrupt neurotransmitter production
These deeper insights help explain symptoms that seem confusing, random, or unrelated.
You receive clear, actionable guidance—not complicated lab printouts.
Our process includes:
- Straightforward explanations of what each result means
- Clear connections between your symptoms and underlying biology
- A full review of findings in a one-on-one consultation
- A personalized plan based on your specific needs
Whether you’re dealing with anxiety, depression, low energy, or cognitive changes, these advanced insights help us target root causes instead of managing symptoms at the surface level.
Whether you’re dealing with anxiety, depression, brain fog, or other mental health challenges, these insights help us create targeted solutions through The BLISS Protocol, addressing root causes rather than just managing symptoms.
Ready to discover what’s really driving your mental health symptoms?
Advanced Blood Panel
Our Advanced Blood Panel looks beyond basic labs to uncover the biological patterns that may be driving your mental health symptoms. Each panel offers a different window into how your body is functioning and helps us tailor your BLISS Protocol treatment plan.
Checks for iron deficiencies or imbalances that can cause fatigue, low mood, or difficulty concentrating.
Evaluates T3, T4, reverse T3, and thyroid antibodies to identify subtle thyroid issues that affect energy, metabolism, and mental well-being.
Assesses heart-related markers tied to inflammation and circulation—both linked to cognitive function.
Provides a detailed look at cholesterol and lipid balance, which can influence vascular health and cognitive performance.
Highlights low-grade inflammation that may contribute to anxiety, depression, and brain fog.
Reveals blood sugar imbalances that often drive mood swings, irritability, and energy crashes.
Measures liver enzymes to assess detoxification and hormonal regulation—two systems closely connected to mental health.
Checks kidney health, which influences fluid balance, blood pressure, and overall resilience.
Screens for anemia, infections, and blood cell imbalances that may impact mood and energy.
Identifies nutrient levels essential for neurotransmitter production, stress response, and emotional stability.
Evaluates leptin levels, which affect appetite, energy regulation, and fatigue.
Detects signs of autoimmune activity that may be contributing to inflammation or mood symptoms.
Assesses hormone patterns that influence stress, mood regulation, focus, and overall vitality.
Functional Medicine Lab Panels with At-Home Collection
Our functional medicine lab panels are designed to be simple and accessible. Many tests use easy at-home collection kits, so you don’t have to visit a lab.
These panels help us understand the deeper causes of anxiety, depression, fatigue, and brain fog. With these insights, Dr. Lewis and her team build a personalized plan that targets your biology—not just your symptoms.

Oxidative Stress and Mental Health
What is the Oxidative Stress Profile?
The Oxidative Stress Profile is an advanced test measuring 16 markers of oxidative damage and 32 genetic variants linked to antioxidant function. It evaluates how well your body handles reactive oxygen species (ROS) and how effectively your cells repair damage.
This test gives a clear picture of your cellular resilience, helping uncover risks for chronic illness and neurological symptoms.
Why Oxidative Stress Matters
Oxidative stress happens when your body has more ROS than it can neutralize. This imbalance can damage your DNA, proteins, and cell membranes. Over time, this contributes to chronic inflammation, neurological disorders, cardiovascular disease, accelerated aging, hormonal imbalance.
Poor diet, stress, toxins, and certain genetic factors can make oxidative stress worse.
Why Order the Oxidative Stress Profile?
Measures DNA, RNA, protein, and lipid damage.
Assesses 32 genetic variants tied to antioxidant activity.
Includes a personalized “Oxidative Damage Score” and offers targeted antioxidant and diet recommendations.
This makes it one of the most complete oxidative stress tests available.
This panel is helpful if you struggle with:
- Chronic fatigue or low stamina
- Joint pain or inflammatory conditions
- Neurological concerns like memory decline
- Cardiovascular risks (high cholesterol or blood pressure)
- High toxin exposure from work or environment
It’s also useful for anyone wanting a deeper look at long-term cellular health.
The Oxidative Stress Profile uses:
- A urine sample to measure oxidative damage
- A saliva sample to evaluate genetic variants (SNPs)
Results highlight areas of low, moderate, or high risk and outline clear next steps.
Markers assessed include:
- DNA Damage: 8-OHdG
- Protein Oxidation: 3-Bromotyrosine, Nitrotyrosine
- Lipid Peroxidation: MDA, 4-HNE
- Genetic Variants: SOD1, CAT, GPX1, and others

Take Control of Your Cellular Health
This test helps you understand how stress, diet, toxins, and lifestyle are affecting your cells. With that information, you can make targeted changes that protect long-term health and mental wellness.
Ready to take action?
Hormones and Mental Health
Hormones deeply influence mood, energy, focus, sleep, and stress tolerance. We use blood, saliva, and urine tests together to get a full picture of how your hormones are working.
Each test type offers unique insights, and combined they give the most accurate view of your hormonal health.
Blood Hormone Testing
Blood tests measure total hormone levels, including both free and protein-bound hormones.
Useful for:
- Checking thyroid function
- Measuring sex hormones
- Assessing adrenal hormones like cortisol
- Tracking changes over time
- Supporting treatment planning for those on oral hormone therapy
Blood testing is considered the gold standard for baseline hormone assessment.

What This Test Measures
This non-invasive, at-home test measures 18 hormone markers across four times in one day, including:
- Estradiol
- Progesterone
- Testosterone
- DHEA-S
- Cortisol patterns (morning, noon, evening, night)
- Cortisone patterns
It offers a snapshot of hormones as they fluctuate throughout the day.
This test is ideal for people experiencing:
- Fatigue or low stress tolerance
- Sugar cravings or weight gain
- PMS or irregular cycles
- Hot flashes or night sweats
- Low libido
- Brain fog or low stamina
- Anxiety or mood shifts
This panel looks at three key hormone groups:
- Sex hormones:
Estradiol, progesterone, testosterone, DHEA-S, and their ratios. These influence mood, energy, libido, and cycle symptoms. - Cortisol patterns:
Cortisol levels in the morning, midday, evening, and at night, plus an overall pooled level. This shows how your stress response shifts across the day. - Cortisone patterns:
Matching diurnal (throughout-the-day) measurements for cortisone, which helps us understand how your body is converting and clearing stress hormones.
Saliva reflects bioavailable hormones—the hormones your tissues can actually use.
Benefits include:
- Clearer view of adrenal function and HPA-axis balance
- Accurate assessment for those using topical or transdermal hormone therapy
- No needles, no stress, no artificial cortisol spikes
- Convenient at-home collection
This makes it a strong complement to blood and urine testing.
Understanding your daily hormone patterns helps guide targeted changes in lifestyle, supplements, and treatment strategies. This test is especially powerful when you’re trying to understand chronic fatigue, stress intolerance, or mood instability.
See how your hormones rise and fall throughout the day.
Simple kits make the process stress-free.
Results guide diet, lifestyle, supplements, and therapy strategies.

Urine Hormone Testing: A Deep Look into Hormone Metabolism
Urine hormone testing shows how your body breaks down and clears hormones, providing insights blood and saliva cannot.
It evaluates:
- Estrogen metabolism (protective vs. harmful pathways)
- Androgen metabolism
- Cortisol production and clearance
- Detoxification efficiency
This test is especially helpful for:
- Fatigue
- Weight changes
- Mood swings
- Sleep issues
- Those on hormone replacement therapy
By combining blood, saliva, and urine data, we create a complete picture of your hormone health and build a plan that matches your body’s needs.
Micronutrient Panel
The Micronutrient Panel is a detailed blood test that measures vitamin, mineral, antioxidant, amino acid, and fatty acid levels inside and outside your cells.
These nutrients affect energy, mood, brain function, immunity, and overall resilience.
By looking at intracellular levels, this test shows both short-term and long-term nutrient status—something standard blood tests often miss.

Nutrient imbalances can quietly fuel symptoms such as:
- Low energy or chronic fatigue
- Depression, anxiety, or mood instability
- Numbness, tingling, or nerve sensitivity
- Weak immune function
- Digestive issues or malabsorption
- Joint pain, muscle weakness, or skin problems
This test doesn’t just reveal deficiencies. It also highlights nutrient excesses or functional declines that may be affecting your physical or mental health.
With this information, we can target the root cause of symptoms rather than guessing.
The Micronutrient Panel may be helpful if you’re experiencing:
- Persistent stress or exhaustion
- Brain fog or memory problems
- Heart or metabolic concerns
- Digestive conditions (IBS, Crohn’s, SIBO)
- Signs of nutrient depletion despite supplements
We measure micronutrients in three ways:
- Serum (extracellular): shows recent nutrient intake
- White blood cells (intracellular): shows long-term nutrient storage
- Red blood cells (RBCs): reflects aging, cognition, and chronic disease markers
Results appear in simple color-coded charts (green, yellow, red), making it easy to see where support is needed.
- Personalized nutrition: Know exactly what your body needs
- Root-cause clarity: Find the reasons behind fatigue, mood issues, or inflammation
- Preventive care: Support immunity, cognitive function, and long-term health
- Targeted guidance: Receive specific food and supplement recommendations
Understanding your micronutrient status gives you a clear, data-driven plan for feeling better. By correcting deficiencies and imbalances, you can support your brain, mood, and overall vitality.
Order Your Micronutrient Panel Today and take the first step toward unlocking your full potential.

Environmental Toxins
This urine-based test measures the amount of harmful environmental chemicals your body is eliminating.
These toxins come from everyday exposures—in air, water, soil, plastics, cleaning products, and personal care items.
Why It Matters for Mental Health
Environmental toxins can interfere with brain function and mood.
Research connects toxin exposure to:
- Fatigue
- Brain fog
- Anxiety and depression
- Cognitive changes
- Neurological symptoms
Knowing your toxin burden helps you reduce exposure and support detoxification pathways.

Using advanced LC-MS/MS technology, the test checks for 38 toxins, including:
- Pesticides (Glyphosate, Atrazine)
- Herbicides (2,4-D)
- Phthalates and parabens
- Volatile organic compounds (VOCs) such as benzene and xylene
Your results are grouped into green, yellow, or red zones so you can easily understand areas of concern.
This test may be helpful if you experience:
- Fatigue or unexplained weakness
- Difficulty concentrating or “foggy” thinking
- Mood swings, anxiety, or low mood
- Neurological symptoms without a clear cause
It’s also a good option if you suspect long-term exposure to pollutants at home, work, or through lifestyle factors.
You receive:
- A simple at-home urine collection
- A detailed report showing exposure levels
- Clear insights on how toxins may be affecting your health
- Guidance on reducing exposure and supporting detox pathways
Understanding your toxin load is a key step toward supporting clearer thinking, a steadier mood, and better overall health. This test can be combined with assessments for heavy metals, gut health, or mycotoxins for a full picture of your wellness.
Order Your Environmental Toxins Test Today and start your journey to a healthier, toxin-free life.
See which specific toxins may be contributing to symptoms such as brain fog, low mood, irritability, or fatigue.
Use your results to create a personalized detox strategy that supports your liver, gut, and natural elimination pathways.
Reducing toxin exposure can improve clarity, stabilize mood, and restore your overall energy and resilience.
Gut Testing

What is the Gut Zoomer?
The Gut Zoomer is an advanced stool test that analyzes more than 170 gut microbes, including bacteria, pathogens, and markers of digestion and inflammation.
It gives a clear picture of your gut health and helps uncover imbalances that may be driving chronic or unexplained symptoms.
This test provides a deep look at your gut microbiome, including:
- Microbial diversity: Finds low levels of beneficial bacteria or overgrowth of harmful species.
- Digestive function: Measures enzyme activity, malabsorption, and gut metabolites.
- Inflammation: Detects immune activity and inflammatory markers.
- Barrier integrity: Screens for intestinal permeability (“leaky gut”).
- Systemic impact: Shows how gut changes may affect your mood, immunity, and hormones.
It’s helpful for identifying root causes of issues like IBS, Crohn’s, autoimmune conditions, eczema, and chronic digestive symptoms.
The test looks at three main categories:
Gut Commensal Microbes: Levels of beneficial and problematic bacteria such as Akkermansia muciniphila and Faecalibacterium prausnitzii.
Gut Pathogens: Harmful bacteria, fungi, protozoa, and viruses.
Key Gut Markers:
Inflammation: Calprotectin, lactoferrin, beta-defensin
Digestion: Pancreatic elastase-1, fecal fats, beta-glucuronidase
Permeability: Zonulin and anti-actin antibodies
The test is helpful for people with:
Bloating, GERD, IBS, or constipation.
Eczema, psoriasis, or unexplained rashes.
Hashimoto’s, rheumatoid arthritis, celiac disease.
Organic Acids
What is the Organic Acids Test?
The Organic Acids Test is a simple urine test that measures 78 metabolic markers. It evaluates your energy production, detox pathways, nutrient levels, gut health, and signs of microbial overgrowth. This helps identify the root causes of stubborn symptoms.

It gives a broad look at:
- Energy metabolism: How well your mitochondria produce energy
- Nutrient status: Vitamin, mineral, and antioxidant needs
- Toxin exposure: Indicators of environmental or dietary toxins
- Oxidative stress: Damage from inflammation and free radicals
- Microbial imbalance: Bacterial, yeast, or mold overgrowth
- Neurotransmitter activity: Metabolites tied to mood and focus
These insights help explain symptoms like fatigue, mood shifts, digestive issues, and cognitive problems.
This test shows what your body needs to function well. It gives you the clarity to take targeted steps toward better energy, digestion, mental clarity, and metabolic balance.
Order Your Organic Acids Test Today and start your journey to optimized wellness.
- Done at home with a first-morning urine sample
- Results show whether each marker is optimal, borderline, or outside the normal range
- Easy-to-read charts make next steps simple
It’s ideal for people with:
- Chronic fatigue or fibromyalgia
- Persistent anxiety, depression, or mood swings
- Bloating, IBS, or unexplained digestive symptoms
- Brain fog or memory problems
- Weight changes or muscle weakness
- Sleep issues or neurological symptoms
Understand what’s driving chronic symptoms.
Targeted lifestyle, supplement, and nutrition plans.
Only one urine sample needed.
One test covers multiple systems.
Mycotoxins
Mycotoxins Test: Understanding Mold-Related Health Risks
What is the Mycotoxins Test?
This urine test measures 29 common mold toxins. Mycotoxins can come from contaminated food or mold in homes or buildings. They affect the immune system, nervous system, and overall energy.
Exposure can lead to:
- Respiratory issues: Chronic sinus problems or shortness of breath
- Neurological symptoms: Brain fog, headaches, memory trouble
- Immune imbalance: Autoimmune activity or frequent illness
- Pain and fatigue: Muscle aches, joint pain, or weakness
- Digestive problems: Bloating, abdominal pain, or diarrhea
This test helps identify which toxins are present and what type of detox support you may need.
If mold is affecting you, this test helps you uncover hidden triggers and take steps toward recovery. It’s useful for both active symptoms and preventive health.
People who may benefit include those who:
- Live or work in damp or water-damaged buildings
- Notice persistent fatigue, brain fog, or breathing issues
- Suspect mold exposure or have a history of exposure
- Have autoimmune conditions or chronic inflammation
Simple at-home urine collection
Results categorize your risk as:
Green: Low
Yellow: Moderate
Red: High
Findings help guide detox strategies and further evaluation
Gut Permeability and Wheat Zoomer
What is the Wheat Zoomer?
The Wheat Zoomer is a highly sensitive blood test that screens for wheat and gluten sensitivity, celiac disease, and signs of intestinal permeability (“leaky gut”).
It measures multiple antibodies to wheat peptides and gluten, giving a clear picture of how your immune system responds to these foods.

This test is helpful if you want to:
- Detect celiac disease or gluten-related autoimmunity
- Identify non-celiac gluten sensitivity
- Check for wheat lectin sensitivity
- Measure intestinal permeability
- Monitor gluten exposure while on a gluten-free diet
- Confirm accidental gluten ingestion
- Get accurate results with 99% specificity and 100% sensitivity
It provides actionable information that supports targeted diet and lifestyle changes.
The test evaluates:
Wheat & Gluten Sensitivity Markers: gliadin, glutenin, wheat germ agglutinin
Celiac Disease Markers: tTG and DGP antibodies
Intestinal Permeability Markers: zonulin, anti-actin, anti-LPS antibodies
Autoimmune Markers: linked to conditions such as dermatitis herpetiformis or gluten ataxia
- No fasting
- No diet changes required (but consistent gluten exposure improves accuracy if you’ve been gluten-free)
- No medication restrictions unless advised by your clinician
This test is ideal for people with:
Bloating, diarrhea, constipation, or abdominal pain.
Brain fog, migraines, memory loss, or tingling sensations.
Thyroid disorders, rheumatoid arthritis, or celiac disease.
Rashes, eczema, or dermatitis herpetiformis
It’s also useful if you have low vitamin D, multiple food sensitivities, or fatigue after meals.
Heavy Metals

What is the Heavy Metals Test?
The Heavy Metals Test measures 20 heavy metals through a blood or urine sample. It helps uncover hidden toxic exposures that may be affecting your brain, metabolism, or overall health.
Heavy metal toxicity is often subtle but can impact almost every system in the body. It may contribute to:
- Neurological issues: memory loss, brain fog, tremors, neuropathy
- Cardiovascular symptoms: high blood pressure, anemia
- Digestive symptoms: nausea, malabsorption, abdominal discomfort
- Reproductive health concerns: infertility or pregnancy issues
- Skin problems: eczema, rashes, unusual pigmentation
This test helps guide detox strategies that fit your specific exposure level.
This test evaluates levels of the following 20 heavy metals: Aluminum, Arsenic, Barium, Beryllium, Cadmium, Cesium, Lead, Mercury, Nickel, Uranium, and more.
Each result is classified as low, moderate, or high risk based on validated reference ranges.
Neural Autoimmunity Panel
What is the Neural Zoomer Test?
The Neural Zoomer is a blood test that measures antibodies linked to neurological autoimmune activity. It helps identify early signs of immune-related damage to the brain, nerves, or protective tissues.

This test offers important benefits:
- Early detection: reveals autoimmune activity before major damage occurs
- Comprehensive insight: evaluates markers related to demyelination, blood-brain barrier integrity, and peripheral nerve health
- Personalized care: helps shape targeted treatment plans and prevention strategies
It’s especially helpful for people with memory changes, chronic pain, neurological symptoms, or family history of autoimmune disease.
Common conditions and symptoms include:
- Cognitive decline, dementia, or Alzheimer’s risk
- Multiple sclerosis or demyelinating conditions
- Traumatic brain injury history
- Depression, anxiety, or unexplained mood shifts
- Neuropathic pain or muscle weakness
- Migraines or visual disturbances
The test evaluates:
- Demyelination antigens: markers of immune-related damage to myelin
- Blood-brain barrier markers: indicators of barrier breakdown
- Peripheral neuropathy markers: immune activity affecting nerve function
It also includes panels for optical, autonomic, and brain-immune markers, offering a full picture of neurological health.
The Neural Zoomer helps you understand potential autoimmune triggers early, so you can get ahead of symptoms and protect long-term brain and nerve function.
Speak with your clinician to see if this test is right for you.

Start with Labs: Your Health Journey Begins Here
Here’s what to expect when you begin:
Comprehensive analysis: advanced labs reveal what’s driving your symptoms
Clear explanations: we review every result with you in simple, understandable language
Action steps: you receive a personalized plan based on your biology
Empowered decisions: you gain the knowledge to move forward with confidence
Begin Your Precision Health Journey
Start with labs to build a strong foundation for your personalized wellness plan.
